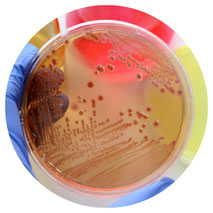
Microbiología

Asesorías Clinícas


Clases personalizadas y asesorías grupales de Bioquímica

Clases personalizadas y asesorías grupales de Farmacología

Clases personalizadas y asesorías grupales de Fisiología

Clases personalizadas y asesorías grupales de Histología

Clases personalizadas y asesorías grupales de Embriología
Clases personalizadas y asesorías grupales de Microbiología